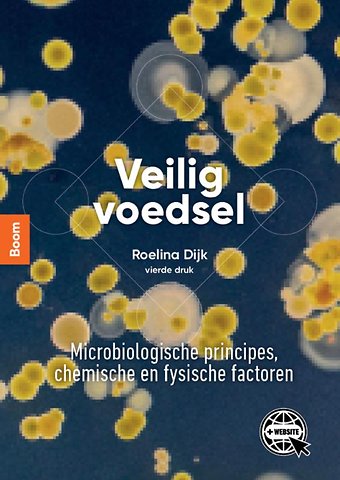

Roelina Dijk is zelfstandig levensmiddelenmicrobioloog. Ze werkt onder meer voor FiMM training & control in food safety.
Meer over Roelina DijkVeilig voedsel
Microbiologische principes, chemische en fysische factoren
Samenvatting
'Veilig voedsel' is een boek dat niet mag ontbreken op de lijst van studenten Voeding & Diëtetiek. Het geeft op heldere wijze inzicht in de factoren die een rol spelen bij de bereiding van veilig voedsel met een focus op de microbiologische kant. Daarnaast gaat het boek ook in op wetgeving en voedselveiligheidssystemen.
Alle denkbare onderwerpen gerelateerd aan voedselveiligheid komen in dit boek aan bod, zoals de groei van micro-organismen, besmetting, bederf, voedselinfecties en/of -vergiftiging, pathogenen, reiniging en desinfectie en de omgang met voedselveiligheidssystemen. Verder worden ook de belangrijkste chemische factoren besproken (waaronder natuurlijke gifstoffen en bestrijdingsmiddelen) en de mogelijke fysieke verontreinigingen van voedsel zoals stukjes glas, metaaldeeltjes en stukjes rubber.
Nieuw
- Het onderdeel HACCP is uitgebreid.
- Elk hoofdstuk bevat een casus waarbij de verschillende uitstroomprofielen van de studenten Voeding & Diëtetiek aan bod komen.
- De praktijkvoorbeelden zijn geactualiseerd.
- Ieder hoofdstuk bevat een definitiekader met de belangrijkste begrippen en definities.
- Achter in het boek bevindt zich een integrale begrippenlijst.
- Het register is volledige geüpdatet.
- Bij het boek hoort een website met o.a. een online versie van het boek
Uniek
Een compleet en concreet studieboek dat ingewikkelde materie toegankelijk en helder uitlegt.
Sluit naadloos aan op het niveau van de hbo-student en is uitermate geschikt voor toepassing in het practicumonderwijs.
Inclusief website met o.a. het online boek:
- MC-oefenvragen bij elk hoofdstuk
- Een begrippentrainer bij elk hoofdstuk
- Online boek
Doelgroep
Studenten die de opleiding Voeding & Diëtetiek volgen of een andere aan voedsel gerelateerde studie, zoals Food & Business
Trefwoorden
Specificaties
Inhoudsopgave
Geraadpleegde bronnen 14
2 Fysische voedselveiligheid 17
2.1 Inleiding 17
2.2 Toelichting en voorbeelden 19
2.3 Aanwezigheid en detectie productvreemde materialen 20
2.4 Radioactieve straling in voedsel 21
Geraadpleegde bronnen 22
Begrippen 22
3 Chemische voedselveiligheid 25
3.1 Inleiding 25
3.2 Toelaatbare innames en maximale limieten 27
3.3 Natuurlijke gifstoffen 28
3.4 Bestrijdingsmiddelen 45
3.5 Gifstoffen via milieuverontreiniging 47
3.6 Diergeneesmiddelen en hormonen 52
3.7 Additieven 55
3.8 Gifstoffen door bereidingsprocessen 55
3.9 Gifstoffen via voedselcontactoppervlakken 58
3.10 Leervragen 61
Geraadpleegde bronnen 62
Begrippen 67
4 Micro-organismen 71
4.1 Inleiding 71
4.2 Soorten micro-organismen 71
4.3 Indeling en naamgeving 72
4.4 Bacteriën 75
4.5 Gisten en schimmels 78
4.6 Protozoën en wormen 81
4.7 Virussen 83
4.8 Leervragen 84
Geraadpleegde bronnen 85
Begrippen 85
5 Groei van micro-organismen 89
5.1 Inleiding 89
5.2 Factoren van invloed op groei 90
5.3 Intrinsieke factoren 91
5.4 Extrinsieke factoren 97
5.5 Impliciete factoren 102
5.6 Leervragen 103
Geraadpleegde bronnen 105
Begrippen 106
6 Kwaliteit en veiligheid van voedsel 109
6.1 Inleiding 109
6.2 Bederf van voedsel 109
6.3 Microbieel bederf 110
6.4 Fermentatie, een vorm van bederf? 111
6.5 Besmettingsbronnen 112
6.6 Levensmiddelenhygiëne 116
6.7 Basisvoorwaardenprogramma (BVP) 117
6.8 Hygiënemaatregelen en persoonlijke hygiëne 118
6.9 Reiniging en desinfectie 120
6.10 Microbiologisch onderzoek: indicatororganismen en totaal kiemgetal 130
6.11 Leervragen 133
Geraadpleegde bronnen 135
Begrippen 136
7 Microbiële voedselveiligheid 139
7.1 Inleiding 139
7.2 Voedselinfectie en/of -vergiftiging 140
7.3 Voedselpathogenen 142
7.4 Overzicht pathogenen 172
7.5 Leervragen 174
Geraadpleegde bronnen 178
Begrippen 181
8 Wetgeving en voedselveiligheidssystemen 185
8.1 Inleiding 185
8.2 Voedselveiligheidswetgeving 186
8.3 Werken met voedselveiligheidssystemen 190
8.4 Rol Nederlandse Voedsel- en Warenautoriteit (NVWA) 195
8.5 Federaal Agentschap voor de veiligheid van de voedselketen (FAVV) in België 197
8.6 Casus HACCP 198
8.7 Leervragen 203
Geraadpleegde bronnen 204
Begrippen 205
Bijlage Achtergrond van processen en technieken 207
Antwoorden bij leervragen 211
Uitwerking casus HACCP 221
Register 227
Illustratieverantwoording 235
Anderen die dit boek kochten, kochten ook
Net verschenen
Rubrieken
- aanbestedingsrecht
- aansprakelijkheids- en verzekeringsrecht
- accountancy
- algemeen juridisch
- arbeidsrecht
- bank- en effectenrecht
- bestuursrecht
- bouwrecht
- burgerlijk recht en procesrecht
- europees-internationaal recht
- fiscaal recht
- gezondheidsrecht
- insolventierecht
- intellectuele eigendom en ict-recht
- management
- mens en maatschappij
- milieu- en omgevingsrecht
- notarieel recht
- ondernemingsrecht
- pensioenrecht
- personen- en familierecht
- sociale zekerheidsrecht
- staatsrecht
- strafrecht en criminologie
- vastgoed- en huurrecht
- vreemdelingenrecht